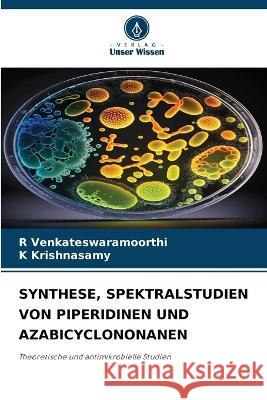
Synthese, Spektralstudien Von Piperidinen Und Azabicyclononanen R Venkateswaramoorthi K Krishnasamy  9786206017066

topmenu
Wyniki wyszukiwania:
wyszukanych pozycji: 5
 |
SINTEZ, SPEKTRAL'NYE ISSLEDOVANIYa PIPERIDINOV I AZABICIKLONONANOV
ISBN: 9786206017172 / Rosyjski / Miękka / 240 str. Termin realizacji zamówienia: ok. 10-14 dni roboczych. |
cena:
195,92 |
 |
Sintesi, Studi Spettrali Di Piperidine E Azabiciclonani
ISBN: 9786206017158 / Włoski Termin realizacji zamówienia: ok. 10-14 dni roboczych. |
cena:
442,38 |
 |
Synthese, Etudes Spectrales Des Piperidines Et Des Azabicyclononanes
ISBN: 9786206017141 / Francuski Termin realizacji zamówienia: ok. 10-14 dni roboczych. |
cena:
442,38 |
|
Synthese, Spektralstudien Von Piperidinen Und Azabicyclononanen
ISBN: 9786206017066 / Niemiecki Termin realizacji zamówienia: ok. 10-14 dni roboczych. |
cena:
442,38 |
 |
Sintese E Estudos Espectrais de Piperidinas E Azabiciclononanos
ISBN: 9786206017165 / Portugalski Termin realizacji zamówienia: ok. 10-14 dni roboczych. |
cena:
442,38 |










